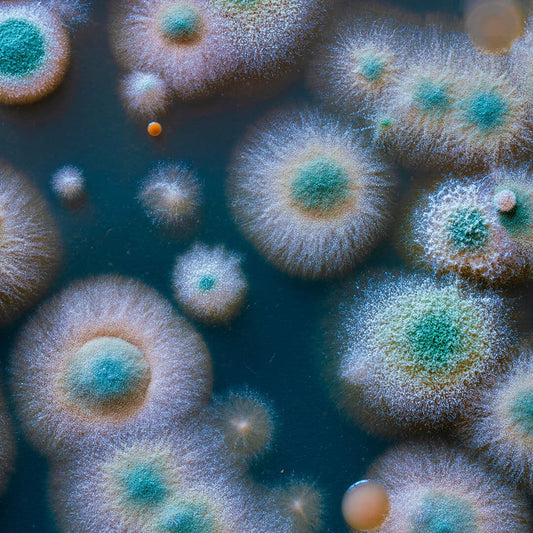

Mould on the window
When the outlook dims
Windows are particularly prone to mould formation, as they are so-called thermal bridges. Condensation collects on the window pane and the moisture also settles in the surrounding walls – quickly, mould spores form and you have mould in the apartment. The only sustainable solution is the drying of the moisture in the wall core.